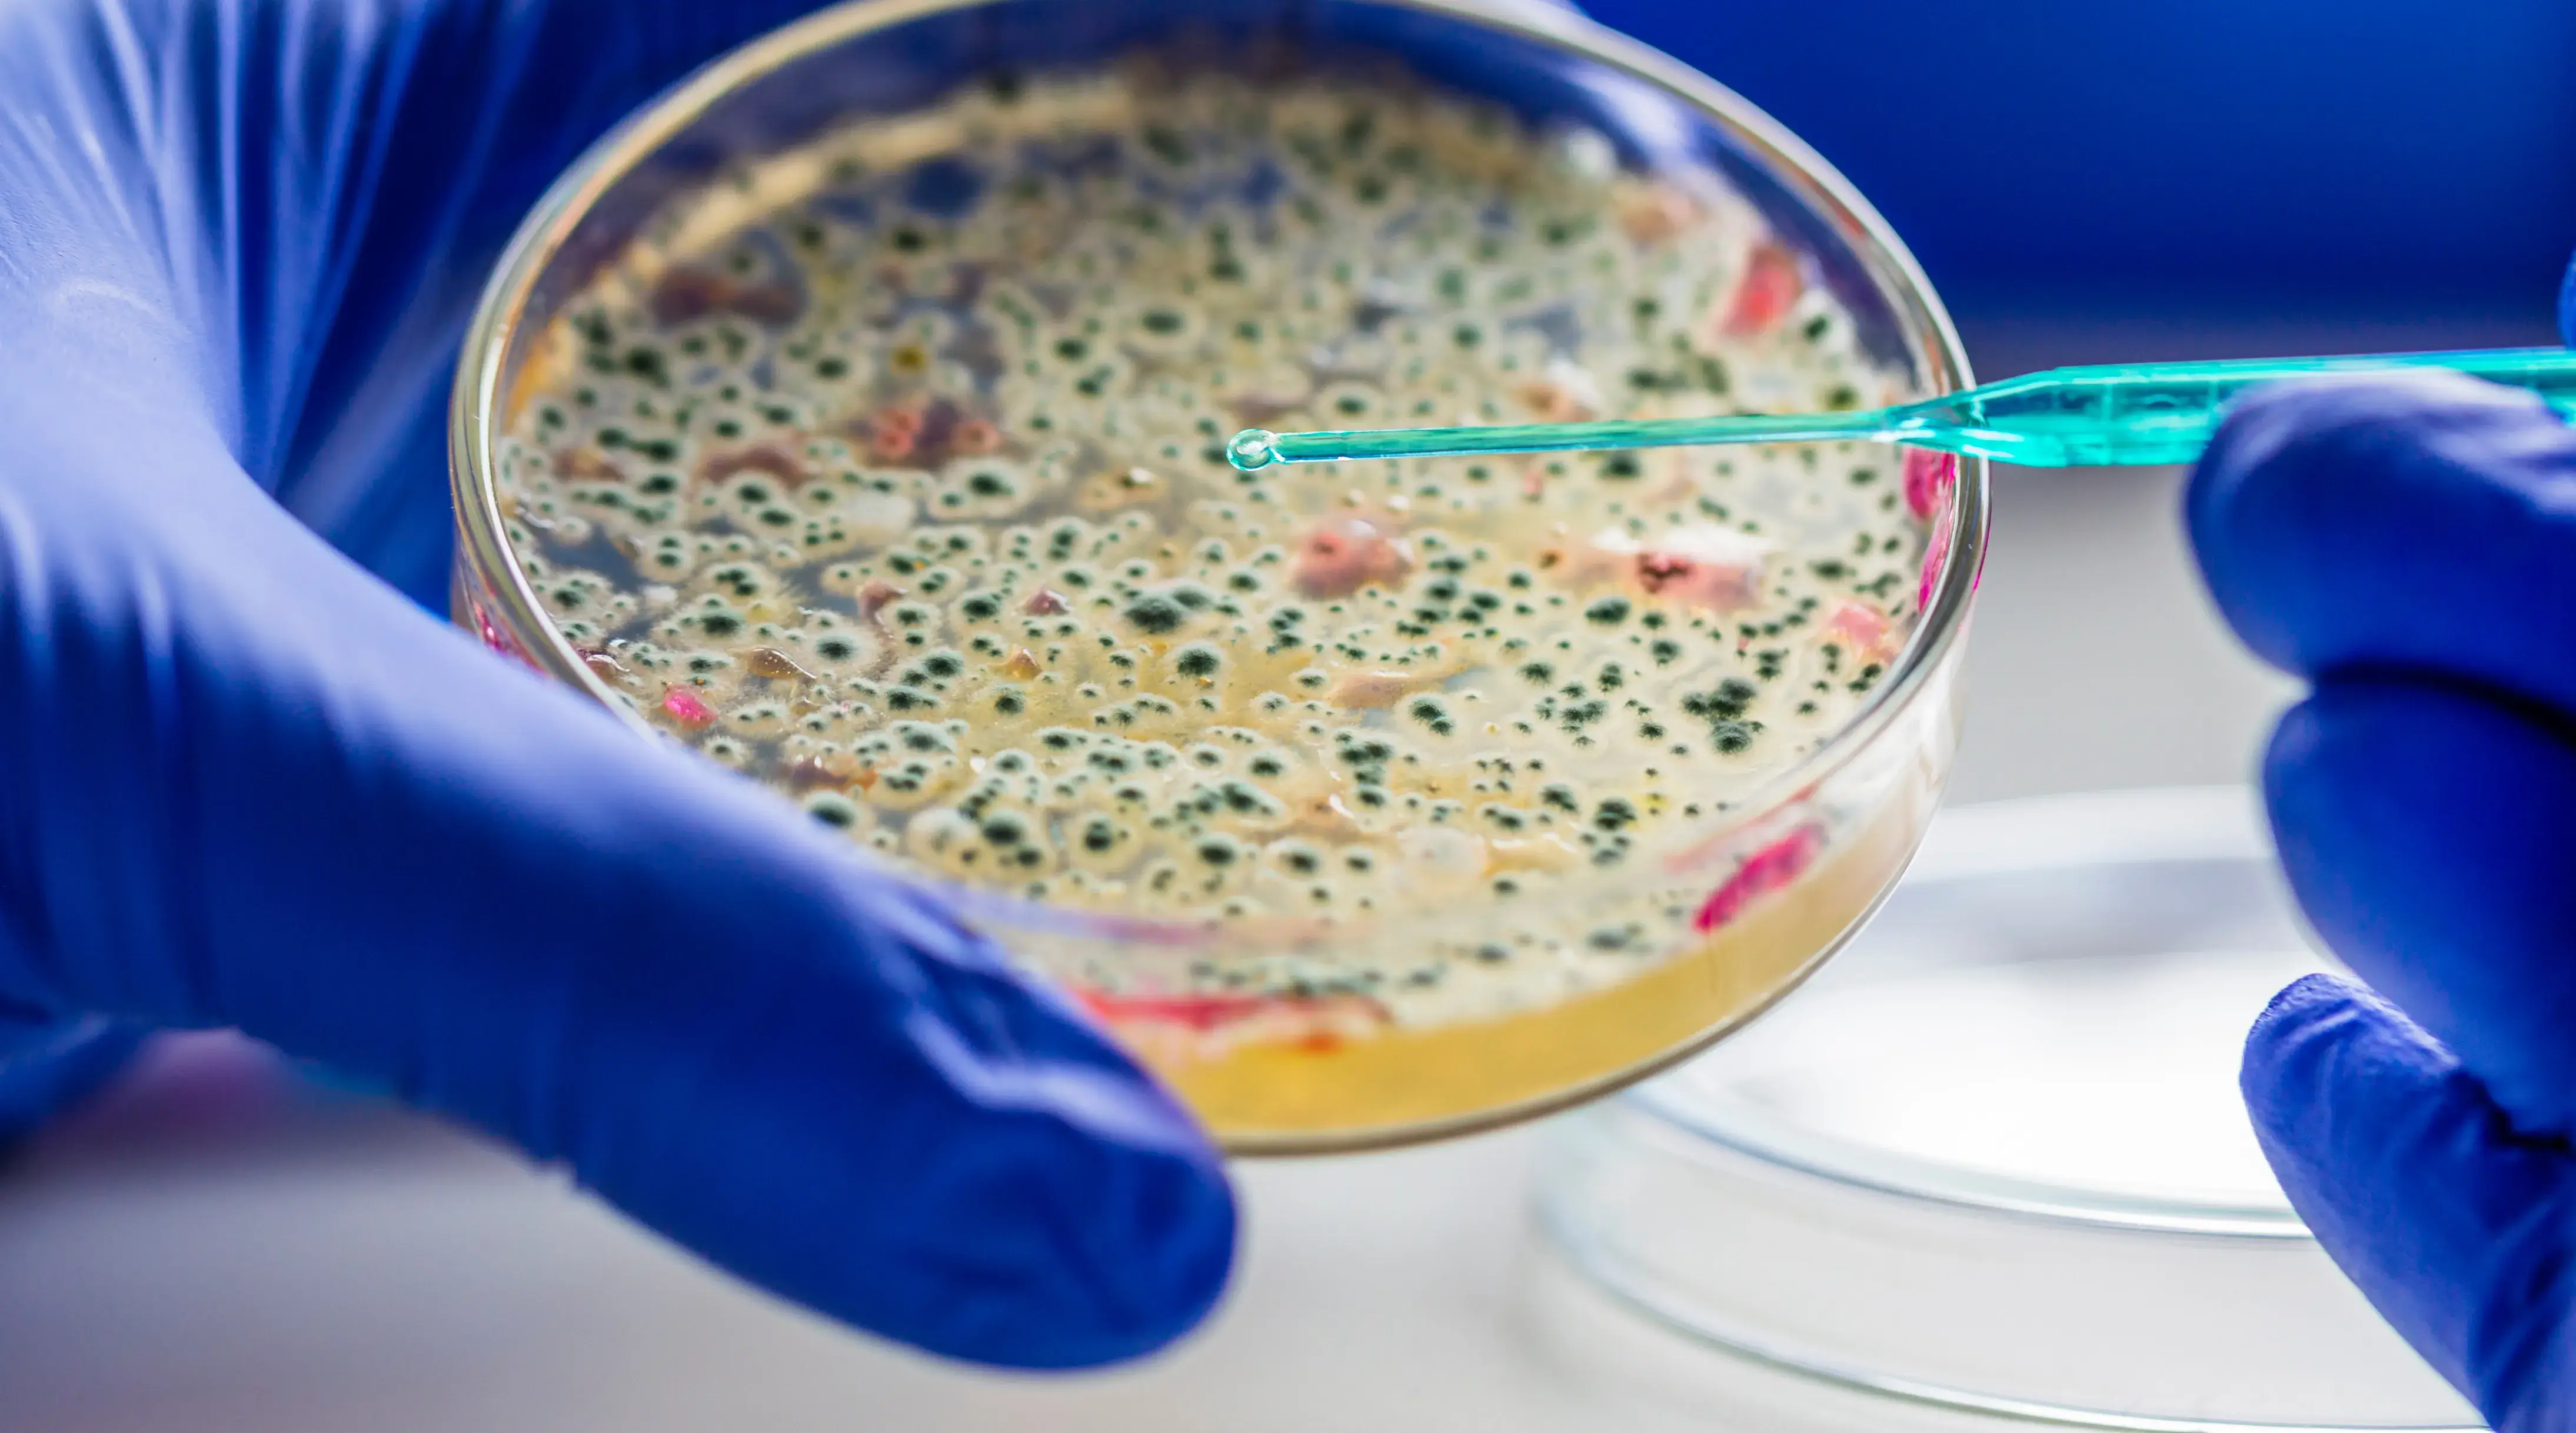
Petri dish with bacterial culture used in FAI Academy online training on antimicrobial resistance (AMR) for veterinarians, farmers, and food supply chain professionals.

"The collaboration with FAI has represented a significant advancement for Finca y Empacadora de Tilapia La Bendicion located in Honduras in strengthening our technical and sustainable capacities across operations. Through the FAI Academy training program, our team has incorporated best practices in animal welfare and environmental management, raising the quality and sustainability standards in tilapia production."
Miguel Madrid
General Manager, Finca y Empacadora de Tilapia La Bendición, Honduras
"Our long-term partnership with FAI supports IKEA's responsible sourcing ambitions. FAI provides clear animal welfare policies, tailored training, and e-learning that help us turn commitments into action. This collaboration strengthens resilience and drives meaningful change throughout our agricultural value chain."
Filippa Blomander
Raw Material Leader-Strategic Direction Agriculture, IKEA
"In 2025, FAI and the World Bank collaborated to deliver a virtual training session 'Learn Blue event' funded by PROBLUE on aquaculture welfare and to develop a dedicated World Bank Open Learning Campus (OLC) training module on this vital topic. These initiatives were crucial in raising awareness and building capacity, providing both internal teams and external stakeholders with rich, evidence-based insights into the importance of animal welfare for sustainable aquaculture."
"As an Aquaculture Specialist, I found the E-Learning courses on tilapia welfare to be extremely practical. They provided me with a clear, welfare-focused approach, which has greatly enhanced my work. I've already recommended the courses to both my colleagues and fish farmers, and using a shared welfare language has made my job much simpler and more effective!"
Sabry Abd El-Aziz
Aquaculture Specialist at Al-Fayrouz Farms, Egypt
"FAI's science-based training and welfare assessments complement our mission to deliver robust and sustainable tilapia genetics. By combining genetics with welfare practices, we are helping farmers achieve stronger performance while upholding standards that benefit both the animals and the industry."
Marina Delphino
Fish Health & Quality Solutions Manager, GenoMar Genetics
"Having added a module focused on the humane management of species to our Agronomic Engineering Career was decisive for the training of the students who are about to graduate. This content elevated their moral outlook and aptitudes in the production of aquatic organisms. The approach, focused on science-based applied knowledge, equips the next generation of experts with the tools to optimize both species health and facility productivity across our region."
Patricio E. Paz, PhD, Associate
Professor of Aquaculture, Department of Agricultural Science and Production, Universidad Zamorano, Honduras
"AQUAVET in partnership with FAI Academy is contributing to the transformation of tilapia farming in Egypt. The training helps bridge the gap between fish health professionals and farmers, giving technical teams a clearer, more practical way to communicate about health, nutrition, water quality, and welfare. With the Tilapia Welfare App and online courses, farmers can assess water, nutrition, and fish behaviour with confidence — turning learning into daily improvement."
Dr Ahmad Hamza
CEO at AQUAVET Egypt
"FAI is a trusted partner supporting our shrimp supply chains in Latin America and Southeast Asia, where they have delivered tailored training (both online and in-person) on shrimp welfare and the assessments and scoring protocol they have developed and implemented into farms. FAI Academy's practical tools and workshops are user-friendly and translated into the local languages, ensuring that farmers and shrimp suppliers have easy access to knowledge and monitoring tools for maintaining and improving shrimp health and welfare across our supply farms."
Shannon Roberts
Aquaculture & Fisheries Biologist at Sea Farms Ltd.
"Partnering with FAI Academy allowed WAVMA to deliver an engaging webinar on fish and shrimp welfare for our global membership of aquatic veterinarians and other related professions attending. The session strengthened veterinarians' and other professionals understanding of welfare science and provided practical tools they can apply in the field. Together, we're helping aquatic health professionals turn welfare knowledge into better outcomes for fish, farmers, and the environment."
Claudia Venegas, DVM, PhD, CertAqV
Aquatic Veterinarian and WAVMA President Elect 2026
"Working with FAI has been an inspiring and valuable experience. Through FAI Academy's training support, our team has gained access to up-to-date knowledge and practical approaches to improving aquatic animal welfare. This collaboration will enable us to integrate fish and shrimp welfare training into our curriculum in the future, contributing to a more responsible and sustainable aquaculture industry."
Tran Minh Phu, Ph.D
Associate Professor, Vice Dean, College of Aquaculture and Fisheries, Can Tho University